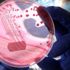

MORE IN NO CATEGORY»

DİSK-AR: Gerçek işsiz sayısı 6 milyon
15 Kasım 2017 15:47
Beşiktaş, Güneş'i TFF'ye bildirdi
15 Kasım 2017 15:00
Trabzonspor'da Burak Yılmaz, Onazi ve Kucka takımla çalıştı
15 Kasım 2017 15:00
Trenin çarptığı çocuk hayatını kaybetti
15 Kasım 2017 15:00
Aksaray Üniversitesinde kavga çıktı, yaralılar var
15 Kasım 2017 15:00
FETÖ şüphelisi noterde yakalandı!
15 Kasım 2017 15:00
Mutfaktan gelen ses 6 kişilik ailenin hayatını kurtardı
15 Kasım 2017 15:00
Okmeydanı'nda minibüs devrildi, trafik felç!
15 Kasım 2017 15:00
Suriye sınırında bin 769 kişi yakalandı
15 Kasım 2017 15:00
Özel harekât 10 ülkenin güvenlik personeline 'özel' eğitim veriy…
15 Kasım 2017 15:00
Hariri 'Lübnan'a döneceğim' açıklamasını yineledi
15 Kasım 2017 15:00
Van’da 2 ton dökme kaçak tütün ele geçirildi
15 Kasım 2017 15:00
Kulüpler Birliği'nden VAR ve yabancı sayısı açıklaması
15 Kasım 2017 15:00
Elektrikli bisiklet tırın altında kaldı, 1 kişi feci şekilde can…
15 Kasım 2017 15:00
Edirne'de suç çetesi çökertildi
15 Kasım 2017 15:00
Cumhurbaşkanı Erdoğan'dan 2019 talimatı!
15 Kasım 2017 14:56
Ünlü spor yazarına büyük şok!
15 Kasım 2017 14:56
TFF'de açıklandı! Şenol Güneş'in sözleşmesi...
15 Kasım 2017 14:56
PKK'nın son taktiği elinde patladı!
15 Kasım 2017 14:56
ABD'ye vize işlemleri normale mi dönüyor?
15 Kasım 2017 14:56
Ahıska Türklerinin sürgün edilişlerinin 73. yılı
15 Kasım 2017 14:56
İnanılmaz rakam! Tek golü 367 bin euro
15 Kasım 2017 14:56
HDP'li vekil tahliye edildi!
15 Kasım 2017 14:56
Tillerson: Görüntüler tek kelimeyle korkunç
15 Kasım 2017 14:56
Kulüpler Birliği'nden VAR ve yabancı sayısı kararı
15 Kasım 2017 14:56
Tuncay Şanlı'dan Altınordu itirafı!
15 Kasım 2017 14:56
26 ilde operasyon! Çok sayıda gözaltı var
15 Kasım 2017 14:56
Avustralya, Rusya biletini rahat aldı!
15 Kasım 2017 14:56
Bakan Tüfenkci'den ucuz et açıklaması
15 Kasım 2017 14:56
Ahmedinejad'a şok! En yakın arkadaşı...
15 Kasım 2017 14:56
Ünlü Türk markasının Bitcoin planı
15 Kasım 2017 14:56
Suçüstü yakalandılar!
15 Kasım 2017 14:56
MDM ödülleri sahiplerini buluyor
15 Kasım 2017 14:52
Şırnak'ta PKK'nın ininde Milan tanksavar roketi çıktı
15 Kasım 2017 14:52
Gen tedavisinde yeni bir yöntem deneniyor
15 Kasım 2017 14:52
'Hastaların yüzde 90'ı KOAH olduğunun farkında değil'
15 Kasım 2017 14:52
Yandaş Turgay Güler'den İzmir Marşı
15 Kasım 2017 14:52
150 MHP'li daha İYİ Parti için istifa etti
15 Kasım 2017 14:52 resimsizYer: Avcılar... Lise öğrencileri sopalarla birbirine girdi
15 Kasım 2017 14:50 resimsizTEM'de minibüs devrildi! Trafikte yoğunluk yaşanıyor
15 Kasım 2017 14:50 resimsizOrta yaşa gelmeden menopoza böyle hazırlanın!
15 Kasım 2017 14:50
Beşiktaş, Güneş'i TFF'ye bildirdi!
15 Kasım 2017 14:50
Gen tedavisinde yeni bir yöntem deneniyor!
15 Kasım 2017 14:50 resimsizÜnlü oyuncudan itiraf: Hem kadınlarla hem de erkeklerle...
15 Kasım 2017 14:50
En güzel 'Doğal Yaşam' fotoğrafları belirlendi
15 Kasım 2017 14:50
KYK burs sonuçları ne zaman açıklanacak?
15 Kasım 2017 14:50 resimsizAres, Ertuğrul'u öldürecek mi?
15 Kasım 2017 14:50
Antika merakı radyo koleksiyoncusu yaptı
15 Kasım 2017 14:50
49 yıl önceki cinayet, Facebook fotoğrafıyla ortaya çıktı!
15 Kasım 2017 14:50 resimsizKoray Avcı ile düet yapacak
15 Kasım 2017 14:50 resimsiz"Biraz emeğe saygı duyun"
15 Kasım 2017 14:50 resimsizHaciz şoku!
15 Kasım 2017 14:50 resimsizOsman Tanburacı saldırıya uğradı!
15 Kasım 2017 14:50 resimsizCevdet, Dağıstanlı'nın hedefinde!
15 Kasım 2017 14:50
Euro rekor üstüne rekor kırıyor!
15 Kasım 2017 14:48
500 milyon dolarlık fonun hepsini harcayacaklar
15 Kasım 2017 14:48
Dünyaca ünlü Yahudi Galerici Max Stern’ın sergisi iptal oldu
15 Kasım 2017 14:48
Bakan Soylu: PKK’ya katılım yüzde 83 azaldı
15 Kasım 2017 14:48
Konut fiyatları yüzde 1.07 yükseldi
15 Kasım 2017 14:48
İstanbul’da dev operasyon
15 Kasım 2017 14:48WHAT'S NEW IN NO CATEGORY»
- Yük treni hemzemin geçitte otomobile çarptı:…
- Corona virüsünün AY.4.2 varyantı bir haftada…
- Cinnet getiren adam karısı ve baldızına kurş…
- İstanbul’da korku dolu anlar…
- Motosikletli 4 saldırgan kurşun yağdırdı
- Narenciye paketleme makinesine kapılan Suriy…
- Bilim dünyası şaştı: HIV vücudundan yok oldu
- Bozcaada’da 7 bin 584 litre sahte şarap ele …
- En fazla kazandıran BES fonları
- İlaçta kriz! TEB: Meslektaşlarımız susturul…
- Twitter’dan önemli adım
- Lukaşenko ve Putin göçmen krizini görüştü
- Bakan Soylu'dan Erdoğan'ın evini görüntüley…
- Bursa'da fabrika yangını!
- Galatasaray’da derbi öncesi kötü haber
- Sahte peygamberin cezası belli oldu! 2021 y…
- Ondokuz Mayıs Üniversitesi duyurdu
- İstanbul Okan 39 Öğretim Üyesi alıyor
- İzmir Ekonomi Üniversitesi açıkladı
- Terörden temizlenen Zap Vadisi seyir tepesi…


